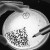

All posts in Salud
-

Fumar 20 cigarros aumenta en 60-90 % probabilidad de infarto
29/09/2015 · No comments
El consumo de tabaco es un factor de riesgo importante de sufrir un infarto agudo…
El extraño caso del bebé Jaxon ‘Strong’ sorprende a médicos
28/09/2015 · No comments
Nacido sin una gran parte de su cráneo y cerebro el pequeño Jaxon Emmett Buell...
Científico ruso se inyecta ‘células eternas’ halladas en Siberia
28/09/2015 · No comments
Rt Actualidad 28/09/2015.- El permanente congelamiento de Siberia permite la vida de unos sorprendentes microorganismos,...
La familia, fundamental para aumentar la donación de órganos
26/09/2015 · No comments
Enterar a la familia sobre la voluntad de donar órganos es la más apremiante tarea...
Recibe IEC doble premio a mejor investigación en oncología biomédica
26/09/2015 · No comments
En el marco de las VII Jornadas Oncológicas de Occidente, dos investigaciones realizadas en el...
Se efectuará la Semana Nacional por un Corazón Saludable
21/09/2015 · No comments
Del 23 al 30 de septiembre se llevará a cabo en el estado la Semana...
Realizarán casi 9 mil acciones de salud para adolescentes
21/09/2015 · No comments
Durante la XI Semana Nacional de Salud de la Adolescencia que comenzó este lunes 21...
Enfermedades cardiovasculares, primera causa de muerte
16/09/2015 · No comments
En México y Colima las enfermedades cardiovasculares (ECV), principalmente el infarto del miocardio y la...
Más equipo para control del dengue y chikungunya
15/09/2015 · No comments
Con las gestiones que viene realizando ante el Centro Nacional de Programas Preventivos y Control...
Desarrollan Cartilla Electrónica de Vacunación en el estado
14/09/2015 · No comments
14/09/2015.- Colima será uno de los primeros cuatro estados de la República que implemente la...
Avisos
Columnistas
Cartelera:
Toma Conciencia
Tiempo
Síguenos
Memes
Finanzas